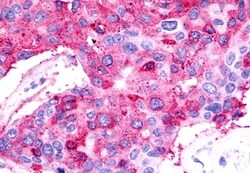
Invitrogen TPRA1 Polyclonal Antibody 50 &mu;g; Unconjugated:Antibodies,

Learn More
Invitrogen™ TPRA1 Polyclonal Antibody


Rabbit Polyclonal Antibody
Brand: Invitrogen™ PA533087
Description
Percent identity with other species by BLAST analysis: Human, Gorilla, Gibbon, Marmoset, Mouse, Rat, Dog, Bovine, Bat, Hamster, Elephant, Panda, Horse, Pig, Platypus (100%); Monkey, Rabbit, Opossum, Turkey, Lizard, Zebrafish (94%); Chicken, Seabass, Salmon, Stickleback (88%). For IHC(P), use heat induced antigen retrieval in pH 6.0 citrate buffer. After incubation with the primary antibody, slides were incubated with biotinylated secondary antibody, followed by alkaline phosphatase-streptavidin and chromogen.
TPRA1 gene ontology (GO) annotations include aging; embryonic cleavage; lipid metabolic process; negative regulation of mitotic cell cycle phase transition.
Specifications
| TPRA1 | |
| Polyclonal | |
| Unconjugated | |
| TPRA1 | |
| 40kDa; FLJ32197; G protein-coupled receptor 175; GPR175; Integral membrane protein GPR175; PP6566; seven transmembrane domain orphan receptor; TMEM227; TPRA1; Tpra40; Transmembrane domain protein of 40 kDa regulated in adipocytes; transmembrane domain protein regulated in adipocytes 40 kDa; transmembrane protein 227; transmembrane protein adipocyte associated 1; transmembrane protein adipocyte-associated 1; transmembrane protein, adipocyte asscociated 1; transmembrane protein, adipocyte associated 1 | |
| Rabbit | |
| Antigen Affinity Chromatography | |
| RUO | |
| 100146781, 100518934, 100768331, 131601, 24100, 484621, 617772, 85494 | |
| Store at 4°C short term. For long term storage, store at -20°C, avoiding freeze/thaw cycles. | |
| Liquid |
| Immunohistochemistry (Paraffin) | |
| 1 mg/mL | |
| PBS with 0.1% sodium azide | |
| Q791F6, Q86W33, Q99MU1 | |
| TPRA1 | |
| Synthetic 17 amino acid peptide from 2nd cytoplasmic domain of human TPRA1 / GPR175. | |
| 50 μg | |
| Primary | |
| Human, Mouse, Rat, Canine, Bovine, Hamster, Pig, Horse, Bat | |
| Antibody | |
| IgG |
Your input is important to us. Please complete this form to provide feedback related to the content on this product.